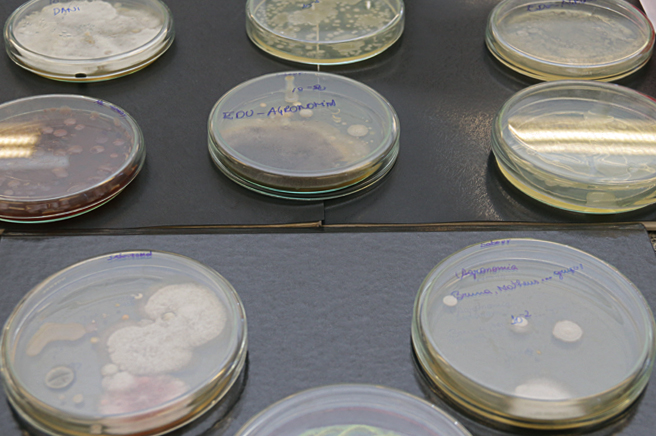

Infraestrutura
Clique abaixo para conhecer a infraestrutura
Laboratório de Botânica Agrícola
No laboratório se trabalha com manejo e conservação da flora, além de divulgar informações sobre as plantas da região.Nele está o Herbário, importante coleção, que constitui fonte de ensino, pesquisa e extensão.
Laboratório de Microbiologia Teoria e Prática
Laboratório de ensino que realiza testes de identificação de microrganismos, colorações para estudo de formas e arranjos, preparação de meio de cultura, técnicas de cultivo e demais técnicas microbiológicas.